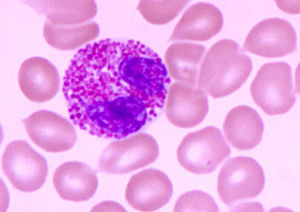

胞質呈嗜酸性的細胞
1. oxyphil cell
從青春期開始,甲狀旁腺內出現嗜酸性細胞,並歲年齡的增長而逐漸增多。

電鏡下,其胞質含豐富的線粒體。
此細胞的功能為介導免疫反應,在寄生蟲感染時增多。在過敏反應中也增多。簡介證明其作用為介導過敏反應,抵禦寄生蟲感染。
2. acidophil
位於垂體腺垂體的遠側部,數量較多,呈圓形或橢圓形,胞質呈嗜酸性,分為兩種:
(1)生長激素細胞 somatotroph
(2)催乳激素細胞mammotroph

嗜酸性細胞 胞質呈嗜酸性的細胞 從青春期開始,甲狀旁腺內出現嗜酸性細胞,並歲年齡的增長而逐漸增多。光鏡下,嗜酸性細胞單個或成群存在於主細胞之間。嗜酸性細胞比主細胞大,但核較小,而且染色深,胞質呈強嗜酸性染色。
嗜酸性粒細胞性胃腸炎(EG)是一種極少見的疾病,本病通常累及胃竇和近端空腸,若一旦累及結腸,則以盲腸及升結腸較多見。按浸潤範圍可分為局限型和瀰漫型。西醫...
概述 臨床表現 診斷標準 鑑別診斷 輔助檢查嗜酸性細胞性肺炎是一組病因明確或尚未明確,以嗜酸性細胞浸潤為特點,常伴周圍血嗜酸細胞增多的疾病。有時稱為嗜酸性細胞增多性肺浸潤(PIE)綜合徵。
簡介 病因學和發病機制 症狀和體徵 診斷 治療人體中正常成熟的白細胞可以分為五類:中性粒細胞、嗜酸性粒細胞、嗜鹼性粒細胞、淋巴細胞和單核細胞。嗜酸性粒細胞是白細胞的組成部分,與其他粒細胞一樣來源於骨...
簡介 形態 作用 臨床意義 正常值參考範圍嗜酸性粒細胞,是由日本David Production公司出品的動漫《工作細胞》及由清水茜編寫漫畫《工作細胞》中的登場角色。對細菌的吞噬能力很弱,主要負...
簡介 形態 作用 臨床意義 正常值參考範圍外周血嗜酸性細胞增多>1500/μl持續6個月或以上;經檢查未發現寄生蟲,過敏或嗜酸性細胞增多的其他原因;器官系統受累或功能異常的臨床表現直接與嗜酸性細...
簡介 病因 症狀 檢查 治療嗜酸細胞增多症骨髓象:1.嗜酸早幼粒細胞2.嗜酸中幼粒細胞3.嗜酸晚幼粒細胞4.嗜酸分葉核粒細胞5.中性中幼粒細胞6.中性分葉核粒細胞7.淋巴細胞8.早...
概述 病因學 診斷 臨床表現 實驗室檢查嗜酸粒細胞白血病(eosinophilic leukemia,EL)是一種罕見的白血病,以外周血及骨髓異常嗜酸性粒細胞增多為特徵,常累及心臟、肺及神經系...
流行病學 病因 發病機制 臨床表現 診斷嗜酸性肉芽腫,是一種孤立性的組織細胞的非腫瘤性質的異常分化。
簡介 臨床表現